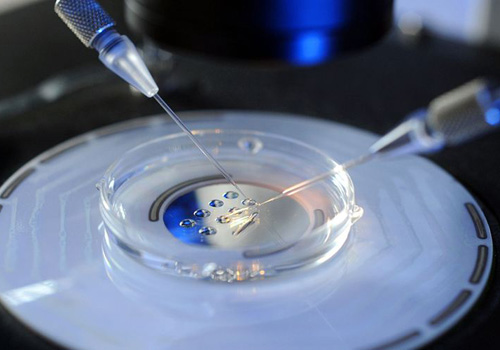
timg (4).jpg

生小孩本来就是一件幸福的事情����,随着人们生活水平和质量要求提高,环境的变化���,增加了很多不孕不育的���,促使生殖方面的医疗技术水平不断提高�����,帮助了很多不孕不育家庭圆了拥有自己宝宝的梦����。在做试管过程中起到决定性因素的挑���,从较根源挑选出优秀的宝宝�,那么俄罗斯试管婴儿是如何筛选优秀宝宝的呢���?
试管婴儿现在被越来越多的人接受��,他的流程相对来说还是比较复杂的����,需要人类辅助生殖技术����,从促排到移植期间�,每一个步通过人工干预��,经过专业实验室胚胎筛查���,将男性精子与女性卵子相结合���,形成胚胎植入子宫,一个新的生命已经开始了����。
那么是如何挑选优秀宝宝的:
第一点,挑选优质的卵子�����,通过促排����,女性可以一次性取出来多个卵子,卵子取出后����,在专业胚胎实验室,光学显微镜下通过卵子形态���,周围包裹的颗粒细胞情况对卵子质量有个初步评估����。
第二点�,挑选优质的精子,选择活力强的���、游的快的精子会被优选出来��,放在一起或者进行单精子注射与卵子结合形成受精卵���。

第三点,挑选优质的胚胎����,如果胚胎发育到囊胚,那么胚胎的潜能是非常大的�����,移植的成功率也会高很多很多�。俄罗斯第三代试管婴儿在胚胎发育分裂过程中��,会提取一个细胞来做染色体的筛查��,没有问题的胚胎才会做移植;胚胎经过层层����,被移植入子宫继续生长的这些胚胎��,着床几率很大�����,避免停胎�����、婴儿畸形等症状产生�。

